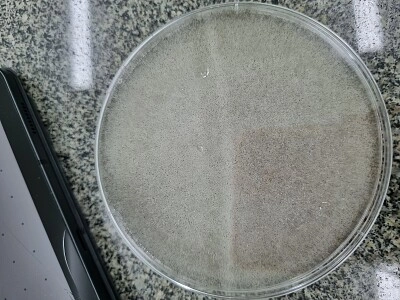

|
||||||||
|
|
||||||||
|
Seu tempo 00:00
|
||||||||
|
Tempo médio
00:06
|
||||||||
|
Melhor tempo
01:18
|
||||||||
 |
||||||||
|
|
||||||||
|
||||||||||||||||||||||||||||
Colônia de zygomicetoEste quebra-cabeça pertence ao dono do álbum Biologia Meu álbum: Ana Paula Alves Dos Reis
Campeão atual: Ana Realizado em: 2024-11-16 Crédito e copyright da foto: Ana |
||||||
| Colônia de zygomiceto - 25 Peças | |||||
| Seu tempo: |
|
||||
| Mostrar peças maiores do quebra-cabeça por trás de peças menores? Sim Não | |
| Compartilhar este jogo |
|
| |